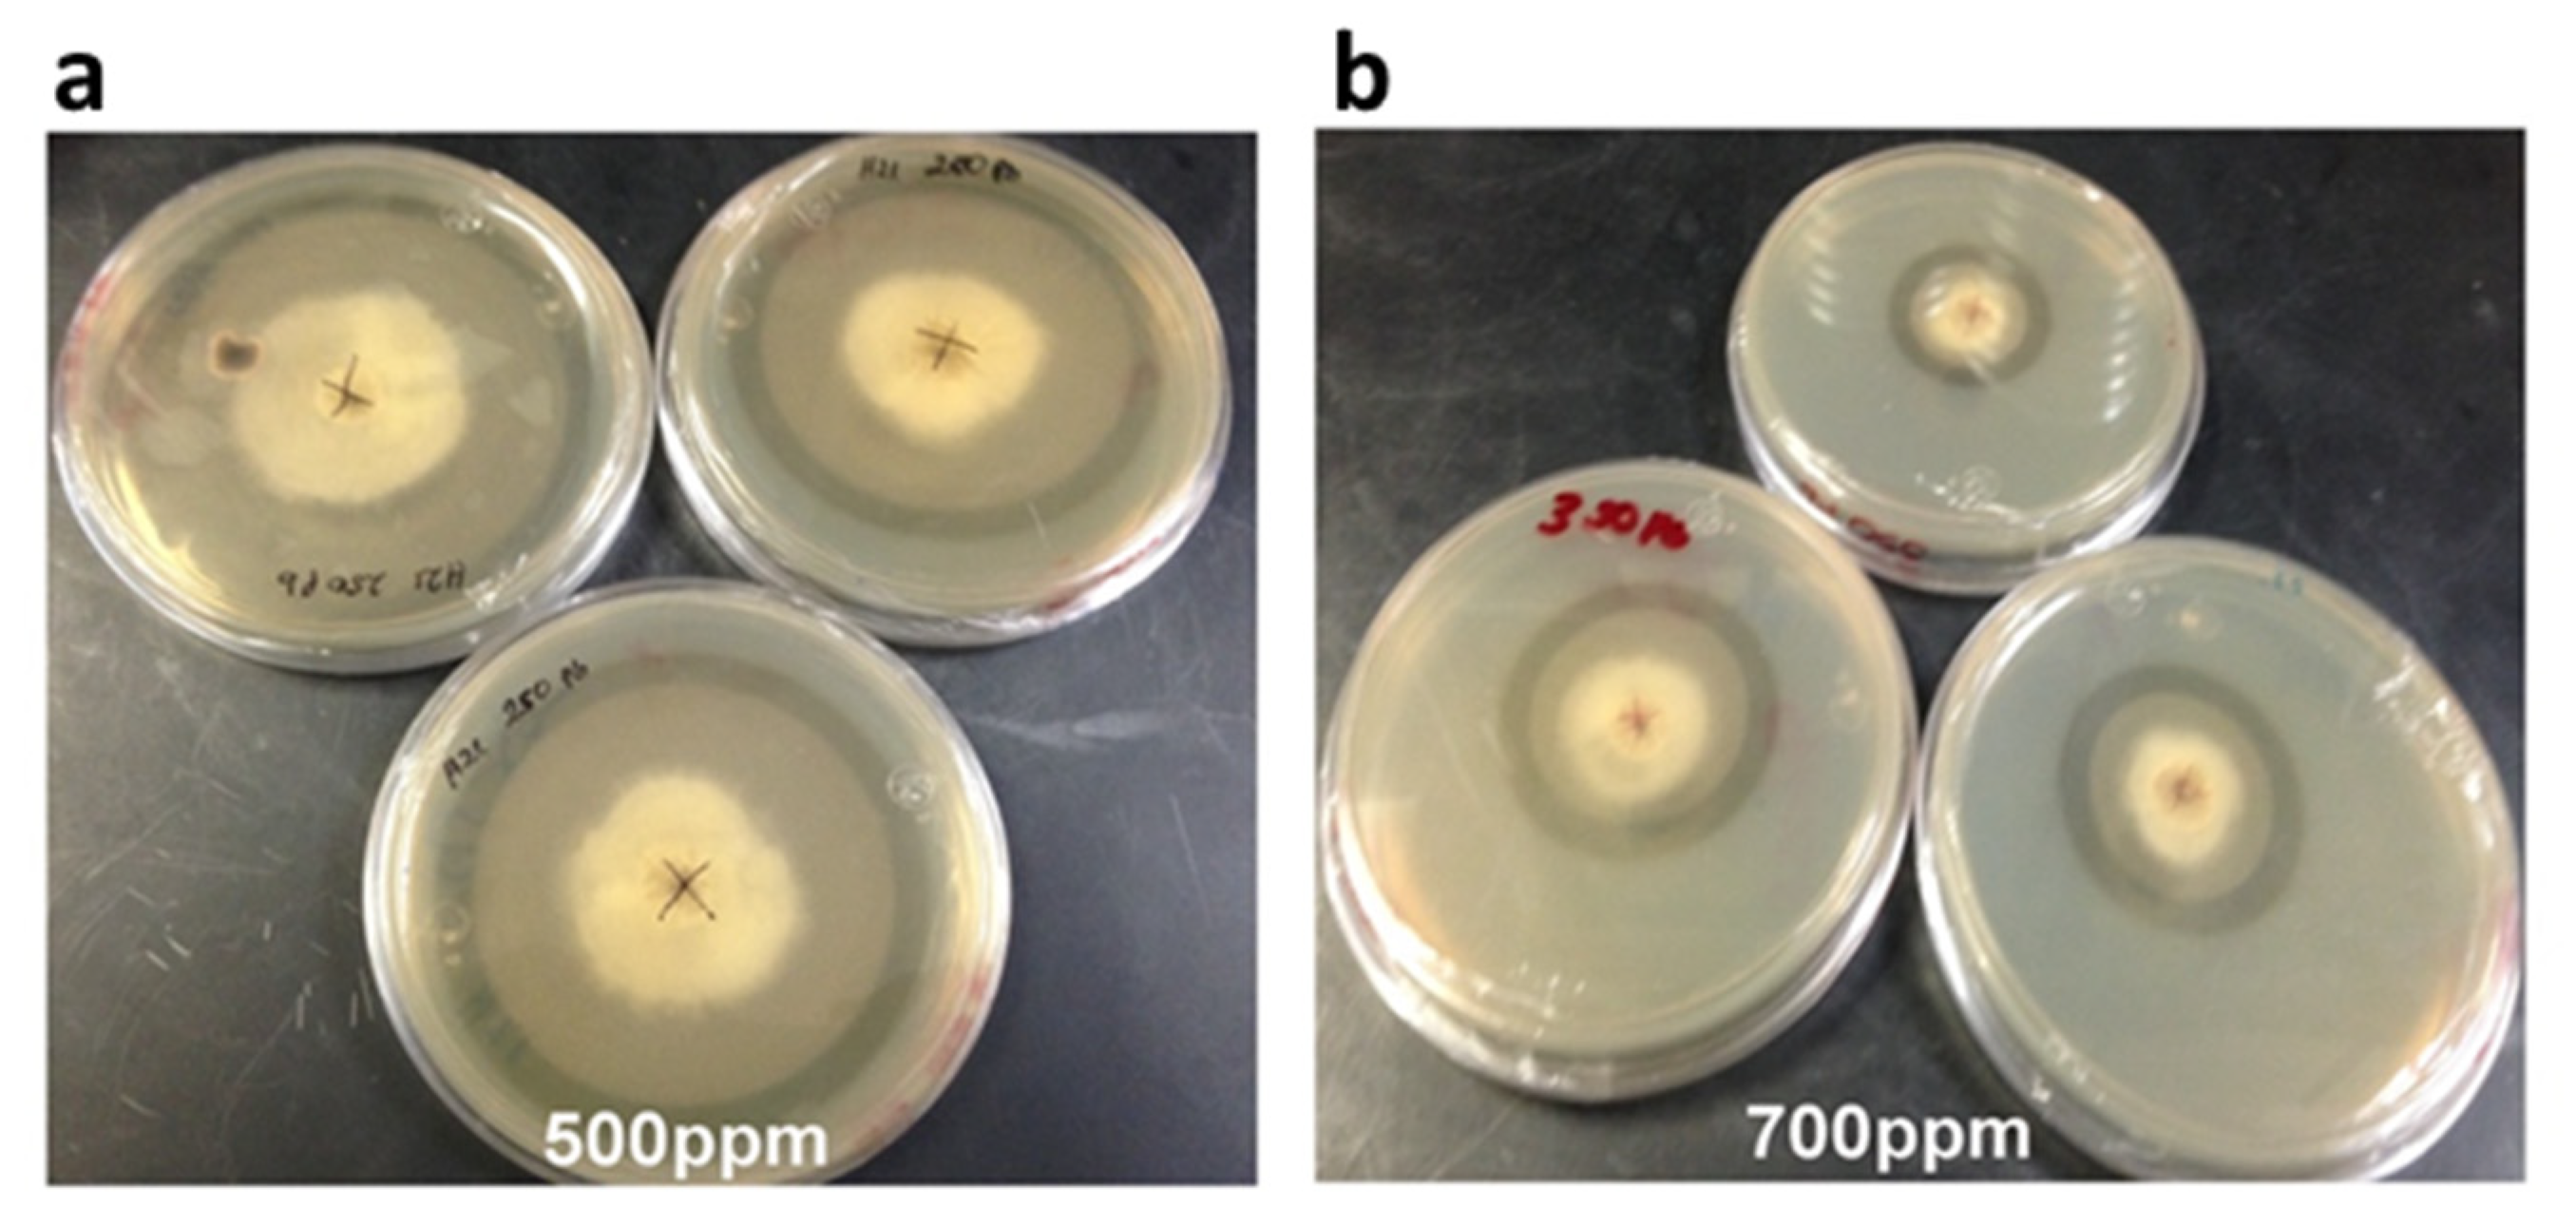
Microorganisms 08 00226 g004

Characterization of Fungal Endophytes Isolated from the Metal Hyperaccumulator Plant Vachellia farnesiana Growing in Mine Tailings
Abstract
1. Introduction
2. Materials and Methods
2.1. Collection Site
2.2. Vachellia farnesiana Sampling and Root Collection
2.3. Fungal Endophyte Isolation
2.4. Identification of Fungal Strains
2.5. Tolerance Tests to Heavy Metals
2.6. Growth Rate and Inhibition of Growth
2.7. Removal of Heavy Metals from Liquid Media
2.8. Organic Acid Determination
2.9. Extraction of Secondary Metabolites and TLC-Metabolic Profiling
2.10. Antioxidant Evaluation
2.10.1. DPPH Bioautography
2.10.2. TEAC-DPPH Assay
2.11. Statistical Analysis
3. Results
3.1. Macroscopic and Microscopic Characterization of Fungal Strains from the Root of V. farnesiana
3.1.1. Strain H17
3.1.2. Strain H21
3.2. Tolerance to Heavy Metals
3.3. Removal of Heavy Metals from Liquid Media
3.4. Organic Acid Production in Response to Lead of Strain H21
3.5. Metabolite Profiling of the H17 Strain with or without Lead
4. Discussion
Supplementary Materials
Author Contributions
Funding
Acknowledgments
Conflicts of Interest
References
- Selvi, A.; Rajasekar, A.; Theerthagiri, J.; Ananthaselvam, A.; Sathishkumar, K.; Madhavan, J.; Rahman, P.K.S.M. Integrated remediation processes toward heavy metal removal/recovery from various environments—A review. Front. Environ. Sci. 2019, 7, 66. [Google Scholar] [CrossRef]
- Cervantes-Ramírez, L.T.; Ramírez-López, M.; Mussali-Galante, P.; Ortiz-Hernández, M.L.; Sánchez-Salinas, E.; Tovar-Sánchez, E. Heavy metal biomagnification and genotoxic damage in two trophic levels exposed to mine tailings: A network theory approach. Rev. Chilena Hist. Nat. 2018, 91, 6. [Google Scholar] [CrossRef]
- Hossain, M.A.; Piyatida, P.; da Silva, J.A.T.; Fujita, M. Molecular mechanism of heavy metal toxicity and tolerance in plants: Central role of glutathione in detoxification of reactive oxygen species and methylglyoxal and in heavy metal chelation. J. Bot. 2012, 2012, 872875. [Google Scholar] [CrossRef]
- Tamás, M.J.; Sharma, S.K.; Ibstedt, S.; Jacobson, T.; Christen, P. Heavy metals and metalloids as a cause for protein misfolding and aggregation. Biomolecules 2014, 4, 252–267. [Google Scholar] [CrossRef] [PubMed]
- Clemens, S. Toxic metal accumulation, responses to exposure and mechanisms of tolerance in plants. Biochimie 2006, 8, 1707–1719. [Google Scholar] [CrossRef]
- Grill, E.; Gekeler, W.; Winnacker, E.-L.; Zenk, H.H. Homo-phytochelatins are heavy metal-binding peptides of homo-glutathione containing Fabales. FEBS Lett. 1986, 205, 47–50. [Google Scholar] [CrossRef]
- Jadia, C.D.; Fulekar, M.H. Phytoremediation of heavy metals: Recent techniques. Afr. J. Biotechnol. 2009, 8, 921–928. [Google Scholar]
- Mishra, J.; Singh, R.; Arora, N.K. Alleviation of heavy metal stress in plants and remediation of soil by rhizosphere microorganisms. Front. Microbiol. 2017, 8, 1706. [Google Scholar] [CrossRef]
- Gadd, G.M.; Bahri-Esfahani, J.; Li, Q.; Rhee, Y.J.; Wei, Z.; Fomina, M.; Liang, X. Oxalate production by fungi: Significance in geomycology, biodeterioration and bioremediation. Fungal Biol. Rev. 2014, 28, 36–55. [Google Scholar] [CrossRef]
- Hall, J.L. Cellular mechanisms for heavy metal detoxification and tolerance. J. Exp. Bot. 2002, 53, 1–11. [Google Scholar] [CrossRef]
- Gupta, V.K.; Nayak, A.; Agarwal, S. Bioadsorbents for remediation of heavy metals: Current status and their future prospects. Environ. Eng. Res. 2015, 20, 1–18. [Google Scholar] [CrossRef]
- Sharma, S.S.; Dietz, K.J.; Mimura, T. Vacuolar compartmentalization as indispensable component of heavy metal detoxification in plants. Plant Cell Environ. 2016, 39, 1112–1126. [Google Scholar] [CrossRef] [PubMed]
- Dunkan, K. Metallothioneins and Related Chelators (Metal Ions in Life Sciences); Sigel, H., Sigel, A., Sigel, R.K.O., Eds.; Royal Society of Chemistry: Cambridge, UK, 2009; Volume 5, pp. 7966–7967. [Google Scholar]
- Hrynkiewicz, K.; Złoch, M.; Kowalkowski, T.; Baum, C.; Buszewsk, B. Efficiency of microbially assisted phytoremediation of heavy-metal contaminated soils. Environ. Rev. 2018, 26, 316–332. [Google Scholar] [CrossRef]
- Dorado, O.; Maldonado, B.; Arias, D.M.; Sorani, V.; Ramírez, R.; Leyva, E.; Valenzuela, D. Programa de Conservación y Manejo Reserva de la Biosfera Sierra de Huautla, 1st ed.; CONANP: México city, México, 2005; pp. 139–170.
- Tovar-Sánchez, E.; Mussali-Galante, P.; Martínez-Pacheco, M.; Ortiz-Hernández, L.; Sánchez-Salinas, E.; Olvera-Velona, A. Relationship between genotoxic damage and arsenic blood concentrations in individuals residing in an arsenic contaminated area in Morelos, Mexico. Rev. Int. Contamin. Amb. 2016, 32, 101–117. [Google Scholar]
- Tovar-Sánchez, E.; Cervantes, L.T.; Martínez, C.; Rojas, E.; Valverde, M.; Ortiz-Hernández, M.L.; Mussali-Galante, P. Comparison of two wild rodent species as sentinels of environmental contamination by mine tailings. Environ. Sci. Pollut. Res. 2012, 19, 1677–1686. [Google Scholar] [CrossRef] [PubMed]
- Mussali-Galante, P.; Tovar-Sánchez, E.; Valverde, M.; Valencia, L.; Rojas, E. Evidence of genetic structure effects in Peromyscus melanophrys populations chronically exposed to mine tailings in Morelos, Mexico. Environ. Sci. Pollut. Res. 2013, 20, 7666–7679. [Google Scholar] [CrossRef] [PubMed]
- Santoyo-Martínez, M. Bioacumulación, Daño Genotóxico y Cambios en la Morfología Foliar de Acacia farnesiana en Los Jales de Huautla, Morelos. Master’s Thesis, Universidad Autónoma del Estado de Morelos, Cuernavaca, Morelos, México, 2017. [Google Scholar]
- Rzedowski, J. Bosque Tropical Caducifolio. In Vegetación de México, 1st ed.; Comisión Nacional para el Conocimiento y Uso de la Biodiversidad (CONABIO): México city, Mexico, 2006; p. 504. [Google Scholar]
- Volke, T.; Velasco, A.; de la Rosa, A.; Solórzano, G. Primer Informe del Proyecto: Evaluación de Tecnologías de Remediación Para Suelos Contaminados con Metales; Dirección General del Centro Nacional de Investigación y Capacitación Ambiental; Instituto Nacional de Ecología y Secretaria de Medio Ambiente y Recursos Naturales: Ciudad de México, México, 2004; p. 43.
- Volke, T.; Velasco, J.; De la Rosa, D. Suelos Contaminados por Metales y Metaloides: Muestreo y Alternativas para su Remediación, 1st ed.; Secretaría de Medio Ambiente y Recursos Naturales; Instituto Nacional de Ecología: Ciudad de México, México, 2005; pp. 19–36.
- Schulz, B.; Wanke, U.; Draeger, S.; Aust, H.J. Endophytes from herbaceous plants and shrubs: Effectiveness of surface sterilization methods. Mycol. Res. 1993, 97, 1447–1450. [Google Scholar] [CrossRef]
- Seifert, K.A.; Gams, W. The genera of Hyphomycetes—2011 update. Persoonia Mol. Phylogen. Evol. Fungi 2011, 27, 119. [Google Scholar] [CrossRef]
- Booth, C. The Genus Fusarium; Commonwealth Mycological Institute: Kew, UK, 1971; p. 237. [Google Scholar]
- Gerlach, W.; Nirenberg, H. The Genus Fusarium—A Pictorial Atlas; Mitteilungen aus der Biologischen Bundesanstalt Für Land- und Forstwirtschaft: Berlin, Germany, 1982; Volume 209, pp. 1–405. [Google Scholar]
- Nelson, P.E.; Toussoun, T.A.; Marasas, W.F.O. Fusarium Species: An Illustrated Manual for Identification; Pennsylvania State University Press: University Park, PA, USA, 1983; p. 183. [Google Scholar]
- Leslie, J.F.; Summerell, B.A. The Fusarium Laboratory Manual, 1st ed.; Blackwell Publishing: Oxford, UK, 2006; p. 387. [Google Scholar]
- Gams, W.; Nirenberg, H.I. A contribution to the generic definition of Fusarium. Mycotaxon 1989, 35, 407–416. [Google Scholar]
- Klich, M.A.; Pitt, J.I. A Laboratory Guide to Common Aspergillus Species and Their Teleomorphs; Division of Food Processing: North Ryde, Australia, 1988. [Google Scholar]
- Kozakiewicz, A. Aspergillus Species on Stored Products; CAB International Mycological Institute: Wallingford, UK, 1989; p. 188. [Google Scholar]
- Klich, M.A. Identification of Common Aspergillus Species; Centraalbureau voor Schimmelcultures: Utrecht, The Netherlands, 2002; p. 116. [Google Scholar]
- Al-Samarrai, T.H.; Schmid, J.A. Simple method for extraction of fungal genomic DNA. Lett. Appl. Microbiol. 2000, 30, 53–56. [Google Scholar] [CrossRef]
- Gouy, M.; Guindon, S.; Gascuel, O. SeaView version 4: A multiplatform graphical user interface for sequence alignment and phylogenetic tree building. Mol. Biol. Evol. 2010, 27, 221–224. [Google Scholar] [CrossRef] [PubMed]
- Guindon, S.; Dufayard, J.F.; Lefort, V.; Anisimova, M.; Hordijk, W.; Gascuel, O. New algorithms and methods to estimate maximum-likelihood phylogenies: Assessing the performance of PhyML 3.0. Syst. Biol. 2010, 59, 307–321. [Google Scholar] [CrossRef] [PubMed]
- Lefort, V.; Longueville, J.E.; Gascuel, O. SMS: Smart Model Selection in PhyML. Mol. Biol. Evol. 2017, 34, 2422–2424. [Google Scholar] [CrossRef] [PubMed]
- Tavaré, S.; Miura, R.M. Some probabilistic and statistical problems in the analysis of DNA sequences. Lect. Math. Life Sci. 1986, 17, 57–86. [Google Scholar]
- Da Silva, F.O.; Itako, A.T.; Júnior, J.B.T. Mycelial growth assessment by digital image analysis in R software environment. IDESIA 2017, 35, 7–10. [Google Scholar]
- Flores-Vallejo, R.C. Aislamiento de Hongos Endófitos de la Especie Medicinal Mexicana Crescentia alata Kunth, Productores de Compuestos Antiinflamatorios y Caracterización Preliminar del Endo- y Exo-Metaboloma Secundario. Master’s Thesis, Centro de Investigación en Biotecnología, Universidad Autónoma del Estado de Morelos, Cuernavaca, Morelos, México, 2017. [Google Scholar]
- Wagner, H.; Bladt, S. Plant Drug Analysis: A Thin Layer Chromatography Atlas; Springer: Berlin, Germany, 1996; p. 384. [Google Scholar]
- Svendsen, A.B.; Verpoorte, R. Chromatography of Alkaloids. Part A: Thin-Layer Chromatography; Elsevier: Amsterdam, The Netherlands, 1983; p. 536. [Google Scholar]
- Huang, Q.; Xu, L.; Qu, W.S.; Ye, Z.H.; Huang, W.Y.; Liu, L.Y.; Lin, J.F.; Ma, H.Y. TLC bioautography-guided isolation of antioxidant activity components of extracts from Sophora flavescens Ait. Eur. Food Res. Technol. 2017, 243, 1127–1136. [Google Scholar] [CrossRef]
- Cieśla, Ł.; Kryszeń, J.; Stochmal, A.; Oleszek, W.; Waksmundzka-Hajnos, M. Approach to develop a standardized TLC-DPPH test for assessing free radical scavenging properties of selected phenolic compounds. J. Pharm. Biomed. 2012, 70, 126–135. [Google Scholar] [CrossRef]
- Fukumoto, L.R.; Mazza, G. Assessing antioxidant and prooxidant activities of phenolic compounds. J. Agric. Food Chem. 2000, 48, 3597–3604. [Google Scholar] [CrossRef]
- Zar, J.H. Biostatistical Analysis, 5th ed.; Prentice Hall: Upper Saddle River, NJ, USA, 2010; p. 932. [Google Scholar]
- Salazar-Ramírez, G. Caracterización de hongos endófitos de Acacia farnesiana con habilidad de tolerar metales pesados. Master’s Thesis, Centro de Investigación en Biotecnología, Universidad Autónoma del Estado de Morelos, Cuernavaca, Morelos, México, 2008. Material not intended for publication. [Google Scholar]
- Sandoval-Denis, M.; Crous, P.W. Removing Chaos from Confusion: Assigning Names to Common Human and Animal Pathogens in Neocosmospora. Persoonia 2018, 41, 109–129. [Google Scholar] [CrossRef]
- Parsa, S.; García-Lemos, A.M.; Castillo, K.; Ortiz, V.; López-Lavalle, L.A.B.; Braun, J.; Vega, F.E. Fungal endophytes in germinated seeds of the common bean, Phaseolus vulgaris. Fungal Biol. 2016, 120, 783–790. [Google Scholar] [CrossRef]
- Bennett, J.W. An overview of the Genus Aspergillus. In Aspergillus molecular biology and genomics; Machida, M., Gomi, K., Eds.; Caister Academic Press: Norfolk, UK, 2010; p. 17. [Google Scholar]
- Domsch, K.H.; Gams, W.; Anderson, T.H. Compendium of Soil Fungi, 2nd ed.; Academic Press: London, UK, 1980. [Google Scholar]
- Wahyuningsih, S.; Wulandari, L.; Wartono, M.W.; Munawaroh, H.; Ramelan, A.H. The effect of pH and color stability of anthocyanin on food colorant. Mater. Sci. Eng. 2017, 193, 12047. [Google Scholar] [CrossRef]
- Hyde, K.D.; Soytong, K. The fungal endophyte dilemma. Fungal Divers. 2008, 33, 163–173. [Google Scholar]
- Eberl, F.; Uhe, C.; Unsicker, S.B. Friend or foe? The role of leaf-inhabiting fungal pathogens and endophytes in tree-insect interactions. Fungal Ecol. 2019, 38, 104–112. [Google Scholar] [CrossRef]
- Maldonado-Magaña, A.; Favela-Torres, E.; Rivera-Cabrera, F.; Volke-Sepulveda, T.L. Lead bioaccumulation in Acacia farnesiana and its effect on lipid peroxidation and glutathione production. Plant Soil 2011, 339, 377–389. [Google Scholar] [CrossRef]
- Alcantara-Martinez, N.; Guizar, S.; Rivera-Cabrera, F.; Anicacio-Acevedo, B.E.; Buendia-Gonzalez, L.; Volke-Sepulveda, T. Tolerance, arsenic uptake, and oxidative stress in Acacia farnesiana under arsenate-stress. Int. J. Phytoremediation 2016, 18, 671–678. [Google Scholar] [CrossRef] [PubMed]
- Armienta, M.A.; Ongley, L.K.; Rodríguez, R.; Cruz, O.; Mango, H.; Villaseñor, G. Arsenic distribution in mesquite (Prosopis laevigata) and huizache (Acacia farnesiana) in the Zimapán mining area, México. Geochem. Explor. Environ. Anal. 2008, 8, 191–197. [Google Scholar] [CrossRef]
- Summerbell, R.C.; Schroers, H.J. Analysis of phylogenetic relationship of Cylindrocarpon lichenicola and Acremonium falciforme to the Fusarium solani species complex and a review of similarities in the spectrum of opportunistic infections caused by these fungi. J. Clin. Microbiol. 2002, 40, 2866–2875. [Google Scholar] [CrossRef]
- O’Donnell, K.; Kistler, H.C.; Tacke, B.K.; Casper, H.H. Gene genealogies reveal global phylogeographic structure and reproductive isolation among lineages of Fusarium graminearum, the fungus causing wheat scab. Proc. Natl. Acad. Sci. USA 2000, 97, 7905–7910. [Google Scholar] [CrossRef]
- Refai, M.; El-Yazid, H.A.; Hassan, A. Monograph on Aspergillus and aspergillosis in man, animals and birds. A Guide for Classification and Identification of Aspergilli, Diseases Caused by Them, Diagnosis and Treatment. 2014. Available online: https://www.researchgate.net/publication/263967669_Monograph_on_Aspergillus_and_Aspergillosis_in_man_animals_and_birds (accessed on 19 July 2014).
- Busby, P.E.; Ridout, M.; Newcombe, G. Fungal endophytes: Modifiers of plant disease. Plant Mol. Biol. 2016, 90, 645–655. [Google Scholar] [CrossRef]
- Jia, M.; Chen, L.; Xin, H.L.; Zheng, C.J.; Rahman, K.; Han, T.; Qin, L.P. A friendly relationship between endophytic fungi and medicinal plants: A systematic review. Front. Microbiol. 2016, 7, 906. [Google Scholar] [CrossRef]
- Asgari, B.; Khadem-Moghadam, N.; Maghsoodi, M.R.; Ghorbanpouraur, M.; Kariman, K. Phytoextraction of heavy metals from contaminated soil, water and atmosphere using ornamental plants: Mechanisms and efficiency improvement strategies. Environ. Sci. Pollut. Res. 2019, 26, 8468. [Google Scholar] [CrossRef] [PubMed]
- Deng, Z.; Cao, L. Fungal endophytes and their interactions with plants in phytoremediation: A review. Chemosphere 2017, 168, 1100–1106. [Google Scholar] [CrossRef] [PubMed]
- Kowshik, M.; Nazareth, S. Biosorption of metals by Fusarium solani. Asian J. Microbiol. Biotechnol. Environ. Sci. 1999, 1, 57–61. [Google Scholar]
- Kowshik, M.; Nazareth, S. Metal tolerance of Fusarium solani. Ecol. Environ. Conserv. 2000, 6, 391–395. [Google Scholar]
- Nicoletti, R.; Fiorentino, A. Plant bioactive metabolites and drugs produced by endophytic fungi of Spermatophyta. Agriculture 2015, 5, 918–970. [Google Scholar] [CrossRef]
- Islam, R.; Datta, B. Characterization of Fusarium solani KUSF204 as a potential metal tolerant plant growth promoting fungus. Int. J. Pharm. Biol. Sci. 2017, 4, 151–161. [Google Scholar]
- Rao, N.; Prabhu, M.; Xiao, M.; Li, W.J. Fungal and bacterial pigments: Secondary metabolites with wide applications. Front. Microbiol. 2017, 8, 1113. [Google Scholar]
- Fomina, M.; Hillier, S.; Charnock, J.M.; Melville, K.; Alexander, I.J.; Gadd, G.M. Role of oxalic acid overexcretion in transformations of toxic metal minerals by Beauveria caledonica. Appl. Environ. Microbiol. 2005, 71, 371–381. [Google Scholar] [CrossRef] [PubMed]
- Ullah, A.; Heng, S.; Munis, M.F.H.; Fahad, S.; Yang, X. Phytoremediation of heavy metals assisted by plant growth promoting (PGP) bacteria: A review. Environ. Exp. Bot. 2015, 117, 28–40. [Google Scholar] [CrossRef]
- El-Bohy, M.N.; Abdel-Monem, Y.K.; Rabie, K.A.; Farag, N.M.; Mahfouz, M.G.; Galhoum, A.A.; Guibal, E. Grafting of arginine and glutamic acid onto cellulose for enhanced uranyl sorption. Cellulose 2017, 24, 1427. [Google Scholar] [CrossRef]

| Strain H17 | |||||||||
|---|---|---|---|---|---|---|---|---|---|
| Metal | Cu | Zn | Pb | ||||||
| ppm | Growth rate 1 | Growth inhibition 2 | SD 3 | Growth rate 1 | Growth inhibition 2 | SD 3 | Growth rate 1 | Growth inhibition 2 | SD 3 |
| PDA | 0.8 | (-) | ± 0.017 | 0.8 | (-) | ± 0.017 | 0.8 | (-) | ± 0.017 |
| 50 | (-) | (-) | (-) | 0.8 | 5 | ± 0.030 | (-) | (-) | (-) |
| 100 | 0.7 | 13 | ± 0.017 | (-) | (-) | (-) | 0.8 | 4 | ± 0.010 |
| 150 | (-) | (-) | (-) | 0.6 | 22 | ± 0.007 | (-) | (-) | (-) |
| 250 | (-) | (-) | (-) | 0.4 | 49 | ± 0.053 | (-) | (-) | (-) |
| 300 | 0.4 | 50 | ± 0.013 | (-) | (-) | (-) | 0.7 | 11 | ± 0.011 |
| 350 | (-) | (-) | (-) | 0.3 | 65 | ± 0.017 | (-) | (-) | (-) |
| 500 | 0.4 | 55 | ± 0.037 | 0.2 | 79 | ± 0.015 | 0.7 | 14 | ± 0.007 |
| 700 | 0 | 100 | ± 0 | 0.1 | 86 | ± 0.01 | 0.7 | 15 | ± 0.010 |
| 1000 | 0 | 100 | ± 0 | (-) | (-) | (-) | 0 | 100 | ± 0 |
| 1400 | 0 | 100 | ± 0 | (-) | (-) | (-) | 0 | 100 | ± 0 |
| Strain H21 | |||||||||
|---|---|---|---|---|---|---|---|---|---|
| Metal | Cu | Zn | Pb | ||||||
| ppm | Growth rate | Growth inhibition | SD 3 | Growth rate | Growth inhibition | SD 3 | Growth rate | Growth inhibition | SD 3 |
| PDA | 0.8 | (-) | ± 0.04 | 0.8 | (-) | ± 0.04 | 0.8 | (-) | ± 0.04 |
| 50 | (-) | (-) | (-) | 0.8 | 5 | ± 0.178 | (-) | (-) | (-) |
| 100 | 0.7 | 7 | ± 0.057 | (-) | (-) | (-) | 0.6 | 30 | ± 0.016 |
| 150 | (-) | (-) | (-) | 0.4 | 47 | ± 0.043 | (-) | (-) | (-) |
| 250 | (-) | (-) | (-) | 0.03 | 95 | ± 0.015 | (-) | (-) | (-) |
| 300 | 0.6 | 21 | ± 0.058 | (-) | (-) | (-) | 0.5 | 41 | ± 0.050 |
| 350 | (-) | (-) | (-) | 0.02 | 97 | ± 0.002 | (-) | (-) | (-) |
| 500 | 0.6 | 30 | ± 0.018 | 0 | 100 | ± 0 | 0.3 | 68 | ± 0.035 |
| 700 | 0.5 | 37 | ± 0.058 | 0 | 100 | ± 0 | 0.1 | 89 | ± 0.033 |
| 1000 | 0.1 | 88 | ± 0.018 | (-) | (-) | (-) | 0 | 100 | ± 0 |
| 1400 | 0 | 100 | ± 0 | (-) | (-) | (-) | 0 | 100 | ± 0 |
| Strain H17 | ||||||||
|---|---|---|---|---|---|---|---|---|
| Combination of Metals (ppm of Each Metal) 1 | ||||||||
| PDA | a | b | c | d | e | f | g | |
| Average growth rate (cm/day) | 0.98 | 0.9 | 0.92 | 0.91 | 0.89 | 0.76 | 0.56 | 0.3 |
| Standard deviation 2 | ± 0.017 | ± 0.018 | ± 0.047 | ± 0.022 | ± 0.005 | ± 0.029 | ± 0.017 | ± 0.013 |
| Average growth inhibition (%) | 0 | 4.1 | 6.1 | 7.1 | 9.2 | 22.4 | 42.9 | 66.3 |
| Strain H21 | |||||
|---|---|---|---|---|---|
| Combination of Metals (ppm of Each Metal) 1 | |||||
| PDA | h | i | j | k | |
| Average growth rate (cm/day) | 1.14 | 1.079 | 0.99 | 0.196 | 0 |
| Standard deviation 2 | ± 0.04 | ± 0.018 | ± 0.035 | ± 0.032 | ± 0 |
| Average growth inhibition (%) | 0 | 5.4 | 13.2 | 74.2 | 100 |
| Organic Acid | Concentration (µg/mL) | |
|---|---|---|
| without Pb | with Pb | |
| Glutamic | ND | 1927.9 ± 53.79 |
| Malic | 11.8 ± 0.82 | 143.1 ± 2.11 |
| Fumaric | 4565.6 ± 7.43 | 324.2 ± 17.57 |
| Succinic | 21.2 ± 0.96 | 89.6 ± 1.83 |
© 2020 by the authors. Licensee MDPI, Basel, Switzerland. This article is an open access article distributed under the terms and conditions of the Creative Commons Attribution (CC BY) license (http://creativecommons.org/licenses/by/4.0/).
Share and Cite
Salazar-Ramírez, G.; Flores-Vallejo, R.d.C.; Rivera-Leyva, J.C.; Tovar-Sánchez, E.; Sánchez-Reyes, A.; Mena-Portales, J.; Sánchez-Carbente, M.d.R.; Gaitán-Rodríguez, M.F.; Batista-García, R.A.; Villarreal, M.L.; et al. Characterization of Fungal Endophytes Isolated from the Metal Hyperaccumulator Plant Vachellia farnesiana Growing in Mine Tailings. Microorganisms 2020, 8, 226. https://doi.org/10.3390/microorganisms8020226
Salazar-Ramírez G, Flores-Vallejo RdC, Rivera-Leyva JC, Tovar-Sánchez E, Sánchez-Reyes A, Mena-Portales J, Sánchez-Carbente MdR, Gaitán-Rodríguez MF, Batista-García RA, Villarreal ML, et al. Characterization of Fungal Endophytes Isolated from the Metal Hyperaccumulator Plant Vachellia farnesiana Growing in Mine Tailings. Microorganisms. 2020; 8(2):226. https://doi.org/10.3390/microorganisms8020226
Chicago/Turabian StyleSalazar-Ramírez, Giovanni, Rosario del Carmen Flores-Vallejo, Julio César Rivera-Leyva, Efraín Tovar-Sánchez, Ayixon Sánchez-Reyes, Julio Mena-Portales, María del Rayo Sánchez-Carbente, María Fernanda Gaitán-Rodríguez, Ramón Alberto Batista-García, María Luisa Villarreal, and et al. 2020. "Characterization of Fungal Endophytes Isolated from the Metal Hyperaccumulator Plant Vachellia farnesiana Growing in Mine Tailings" Microorganisms 8, no. 2: 226. https://doi.org/10.3390/microorganisms8020226
APA StyleSalazar-Ramírez, G., Flores-Vallejo, R. d. C., Rivera-Leyva, J. C., Tovar-Sánchez, E., Sánchez-Reyes, A., Mena-Portales, J., Sánchez-Carbente, M. d. R., Gaitán-Rodríguez, M. F., Batista-García, R. A., Villarreal, M. L., Mussali-Galante, P., & Folch-Mallol, J. L. (2020). Characterization of Fungal Endophytes Isolated from the Metal Hyperaccumulator Plant Vachellia farnesiana Growing in Mine Tailings. Microorganisms, 8(2), 226. https://doi.org/10.3390/microorganisms8020226

